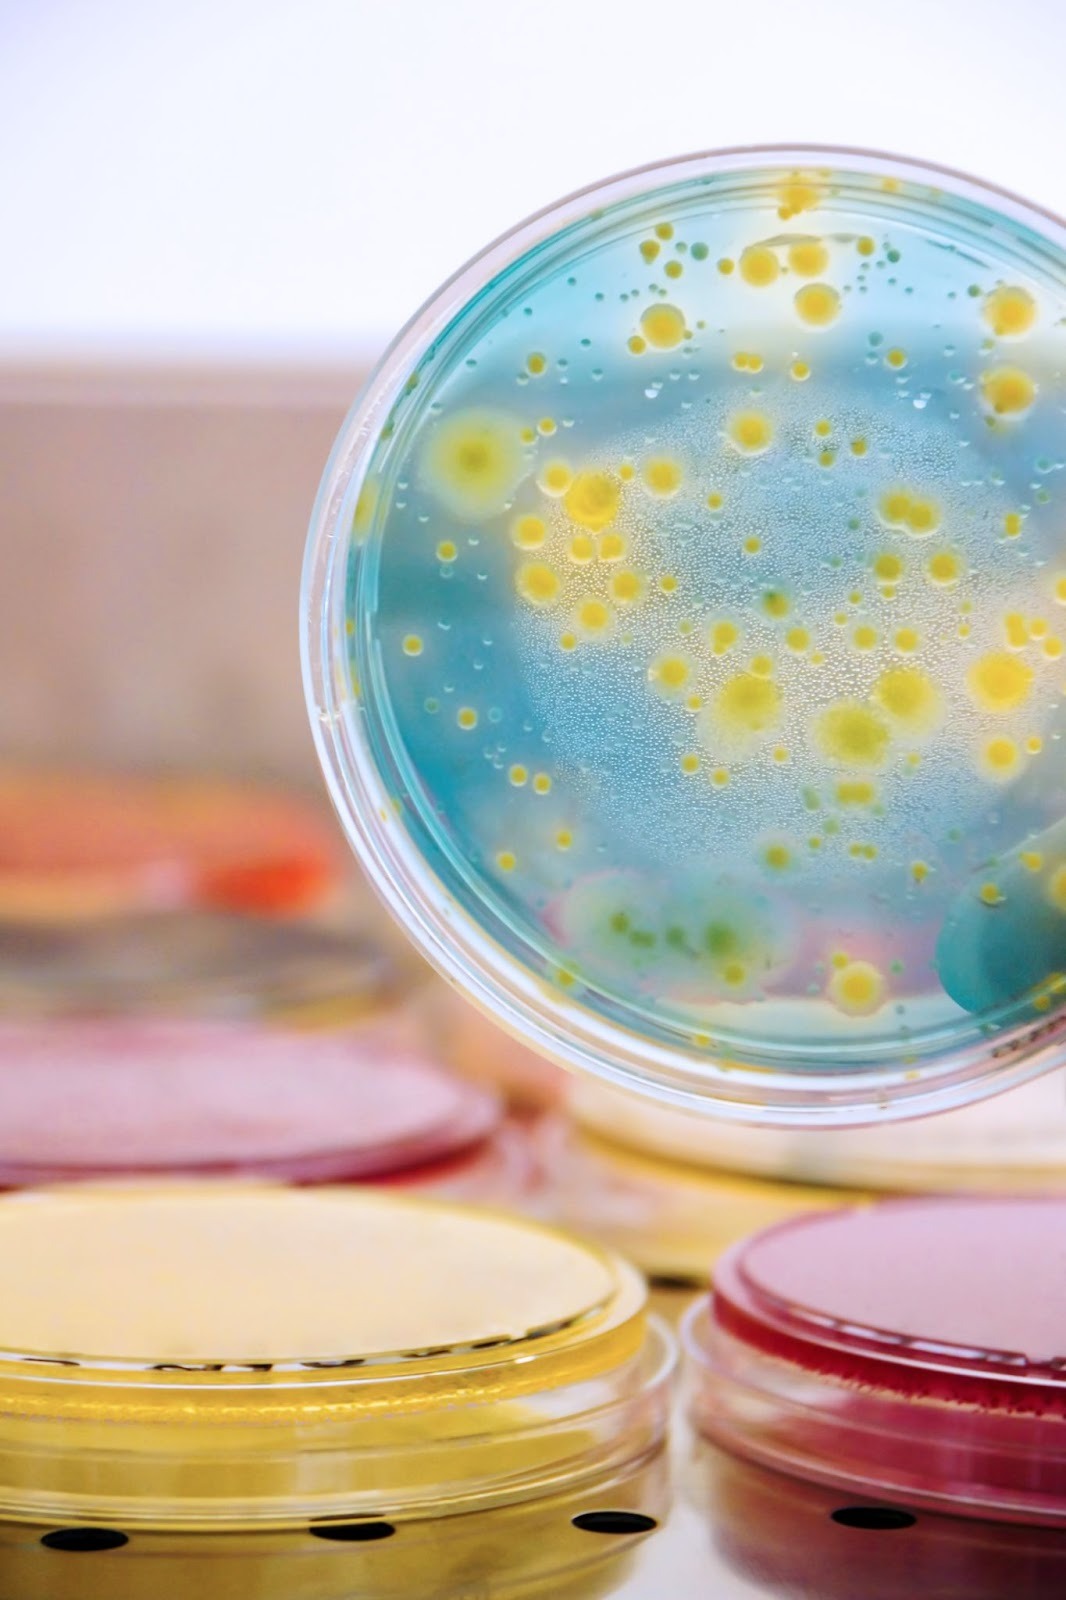

Was ist Brottrunk eigentlich?
Brottrunk ist ein natürlich vergorenes Getränk, das auf Basis von Vollkornbrot entsteht. Durch den Fermentationsprozess entwickeln sich wertvolle Milchsäurebakterien, die wie kleine Helfer im Darm wirken. Aus ernährungsberaterischer Sicht ist Brottrunk deshalb kein „neues Wundermittel“, sondern ein traditionelles Lebensmittel, das wir gezielt nutzen können, um die Verdauung und das allgemeine Wohlbefinden zu unterstützen.

Ursprung und Herstellung
Die Geschichte des Brottrunks reicht bis in die traditionelle Brotkultur zurück. Aus frisch gebackenem Vollkornbrot, Wasser und speziellen Mikroorganismen entsteht durch milchsaure Gärung ein fermentiertes Getränk. Dieser Prozess läuft ganz ohne Zusätze oder Zucker ab – und genau das macht Brottrunk so rein und bekömmlich.
Wichtige Inhaltsstoffe
Brottrunk enthält eine Vielzahl an aktiven Milchsäurebakterien, die zur Balance der Darmflora beitragen können. Außerdem liefert er B-Vitamine, Mineralstoffe wie Magnesium und Eisen sowie natürliche Enzyme. Diese Kombination wirkt regulierend auf den Verdauungstrakt, unterstützt das Immunsystem und kann langfristig das Gleichgewicht im Stoffwechsel fördern.

Warum Brottrunk beim Abnehmen helfen kann
Brottrunk ist kein Wundermittel, aber er kann den Körper auf natürliche Weise beim Abnehmen unterstützen. Der Schlüssel liegt in seiner Wirkung auf Stoffwechsel und Darmflora – zwei zentrale Faktoren, die eng mit unserem Gewicht zusammenhängen.
Wirkung auf den Stoffwechsel
Durch die Fermentation enthält Brottrunk zahlreiche aktive Mikroorganismen und Enzyme. Diese unterstützen:
- eine bessere Verwertung von Nährstoffen
- die Anregung der Verdauung
- einen insgesamt aktiveren Stoffwechsel
Dadurch fühlt man sich oft weniger müde nach dem Essen und die Energie wird effizienter genutzt.
Weniger Heißhunger durch bessere Darmflora
Ein gesunder Darm spielt eine entscheidende Rolle bei der Gewichtskontrolle. Die Milchsäurebakterien im Brottrunk helfen dabei, das Gleichgewicht der Darmflora zu stabilisieren. Das kann bewirken:
- weniger Heißhungerattacken
- ein stabilerer Blutzuckerspiegel
- mehr Kontrolle über das eigene Essverhalten
So fällt es leichter, Mahlzeiten bewusster zu genießen und unnötige Kalorienfallen zu umgehen.

Die Rolle der Darmgesundheit
Unsere Darmgesundheit beeinflusst weit mehr als nur die Verdauung. In der Ernährungsberatung sehe ich immer wieder, dass ein gesunder Darm ein entscheidender Faktor für das Wohlbefinden und auch für das Gewicht ist.
Zusammenhang zwischen Darm und Gewicht
Der Darm ist nicht nur für die Aufnahme von Nährstoffen zuständig, sondern auch für die Regulierung vieler Stoffwechselprozesse. Gerät die Darmflora aus dem Gleichgewicht, kann das Folgen haben:
- die Verdauung wird träge
- Nährstoffe werden schlechter verwertet
- der Stoffwechsel arbeitet langsamer
- das Risiko für Gewichtszunahme steigt
Ein gesunder Darm hingegen sorgt dafür, dass der Körper optimal versorgt ist und leichter in Balance bleibt.
Darmflora als Schlüssel zum Wohlbefinden
Unsere Darmflora besteht aus Milliarden von Bakterien – sowohl „guten“ als auch weniger hilfreichen. Das richtige Gleichgewicht entscheidet darüber, wie wir uns fühlen. Eine stabile Darmflora kann:
- das Immunsystem stärken
- Heißhunger regulieren
- die Verdauung harmonisieren
- das allgemeine Wohlbefinden fördern
Hier setzt Brottrunk an: Die enthaltenen Milchsäurebakterien können die Vielfalt und Stabilität der Darmflora unterstützen – ein wichtiger Baustein, wenn Abnehmen und Gesundheit Hand in Hand gehen sollen.

Gesundheitliche Vorteile von Brottrunk
Brottrunk bringt gleich mehrere Vorteile für die Gesundheit mit sich. Besonders bemerkenswert ist seine Wirkung auf das Immunsystem und die Verdauung.
Stärkung des Immunsystems
Ein Großteil unserer Abwehrkräfte sitzt im Darm. Wenn die Darmflora im Gleichgewicht ist, können Krankheitserreger besser abgewehrt werden und der Körper wirkt insgesamt widerstandsfähiger. Durch die im Brottrunk enthaltenen Milchsäurebakterien wird dieses Gleichgewicht gezielt gefördert. Viele Menschen berichten, dass sie sich nach einigen Wochen regelmäßigen Trinkens weniger anfällig für Infekte fühlen und mehr Energie im Alltag haben.
Unterstützung der Verdauung
Auch die Verdauung profitiert spürbar. Die aktiven Mikroorganismen im Brottrunk regen die Verdauung sanft an und tragen dazu bei, Blähungen oder Völlegefühl zu reduzieren. Gleichzeitig verbessert sich die Aufnahme von Nährstoffen, was sich positiv auf das gesamte Wohlbefinden auswirken kann. Wer Brottrunk regelmäßig in den Alltag integriert, erlebt häufig ein leichteres Bauchgefühl und mehr Balance im Verdauungssystem.

Brottrunk richtig in den Alltag integrieren
Viele Menschen sind unsicher, wie sie Brottrunk am besten trinken sollen. Die gute Nachricht: Es ist unkompliziert und lässt sich leicht in den Alltag einbauen.
Wann und wie viel trinken?
Für den Einstieg reicht es, ein kleines Glas pro Tag zu trinken, am besten morgens auf nüchternen Magen oder zwischen den Mahlzeiten. Wer empfindlich reagiert, kann mit nur ein paar Schlucken beginnen und die Menge langsam steigern. Wichtig ist, den Körper an die probiotischen Kulturen zu gewöhnen.
Praktische Tipps für Einsteiger
Brottrunk hat einen recht herben, leicht säuerlichen Geschmack, der anfangs ungewohnt sein kann. Manche trinken ihn pur, andere mischen ihn gerne mit Wasser oder einem Schuss Saft, um den Geschmack milder zu machen. Auch in Smoothies oder als Basis für ein Salatdressing kann er genutzt werden – so wird er nicht nur bekömmlich, sondern auch vielseitig.

Mögliche Nebenwirkungen & Verträglichkeit
Brottrunk ist grundsätzlich ein sehr natürliches und gut verträgliches Getränk. Trotzdem kann es gerade am Anfang vorkommen, dass der Körper ein bisschen Zeit braucht, um sich an die vielen neuen Milchsäurebakterien zu gewöhnen. Das ist völlig normal und kein Grund zur Sorge.
Wer vorsichtig sein sollte
Besonders sensible Menschen oder Personen mit einem empfindlichen Magen können zu Beginn leichte Reaktionen wie Blähungen oder ein ungewohntes Bauchgefühl spüren. Auch wer generell schnell auf fermentierte Lebensmittel reagiert, sollte lieber mit einer kleinen Menge starten. Für die allermeisten ist Brottrunk aber gut verträglich und schon nach kurzer Eingewöhnungszeit problemlos zu genießen.

Tipps bei anfänglichen Beschwerden
Falls es am Anfang etwas „rumort“, hilft es, wirklich klein anzufangen – zum Beispiel mit nur ein paar Schlucken pro Tag. Danach kann die Menge Schritt für Schritt gesteigert werden. Viele mischen Brottrunk auch gerne mit Wasser oder Saft, um den Geschmack milder und die Verträglichkeit angenehmer zu machen. Nach einigen Tagen hat sich der Körper in der Regel daran gewöhnt, und das positive Bauchgefühl stellt sich von ganz allein ein.

Fazit: Dein Weg zu mehr Gesundheit mit Brottrunk
Aus meiner Erfahrung als Ernährungsberaterin und Personal Trainerin weiß ich, wie eng Ernährung, Bewegung und Wohlbefinden zusammenhängen. Brottrunk ist dabei kein Zaubertrank, aber er kann ein wertvoller Baustein sein, wenn es darum geht, den Körper in Balance zu bringen und das eigene Ziel – sei es Abnehmen, mehr Energie oder eine bessere Verdauung – leichter zu erreichen.
Besonders schätze ich an Brottrunk, dass er so natürlich ist: keine künstlichen Zusätze, keine leeren Versprechen, sondern ein ehrliches Lebensmittel, das deinen Darm und damit dein gesamtes System stärken kann. Genau das ist es, was nachhaltige Veränderungen ausmacht – kleine, alltagstaugliche Schritte, die man langfristig durchhält.
Wenn du Brottrunk in deinen Alltag einbaust, wirst du schnell merken, dass sich dein Körper leichter anfühlt, Heißhunger seltener auftritt und dein Wohlbefinden insgesamt steigt. Als Coach rate ich meinen Klient:innen immer: Probier es einfach aus, fang mit kleinen Mengen an und spür selbst, wie dein Körper reagiert.
Und falls du dir Unterstützung wünschst, bin ich genau dafür die richtige Ansprechpartnerin. Ob es um Ernährung, Gewichtsmanagement, Darmgesundheit oder ein ganzheitliches Training geht – gemeinsam finden wir den Weg, der zu deinem Leben passt.
Denn am Ende ist es genau das Zusammenspiel aus Ernährung, Bewegung und einer gesunden Darmflora, das dich deinem persönlichen Ziel ein Stück näherbringt. Und Brottrunk kann dich dabei sanft, aber wirkungsvoll unterstützen.